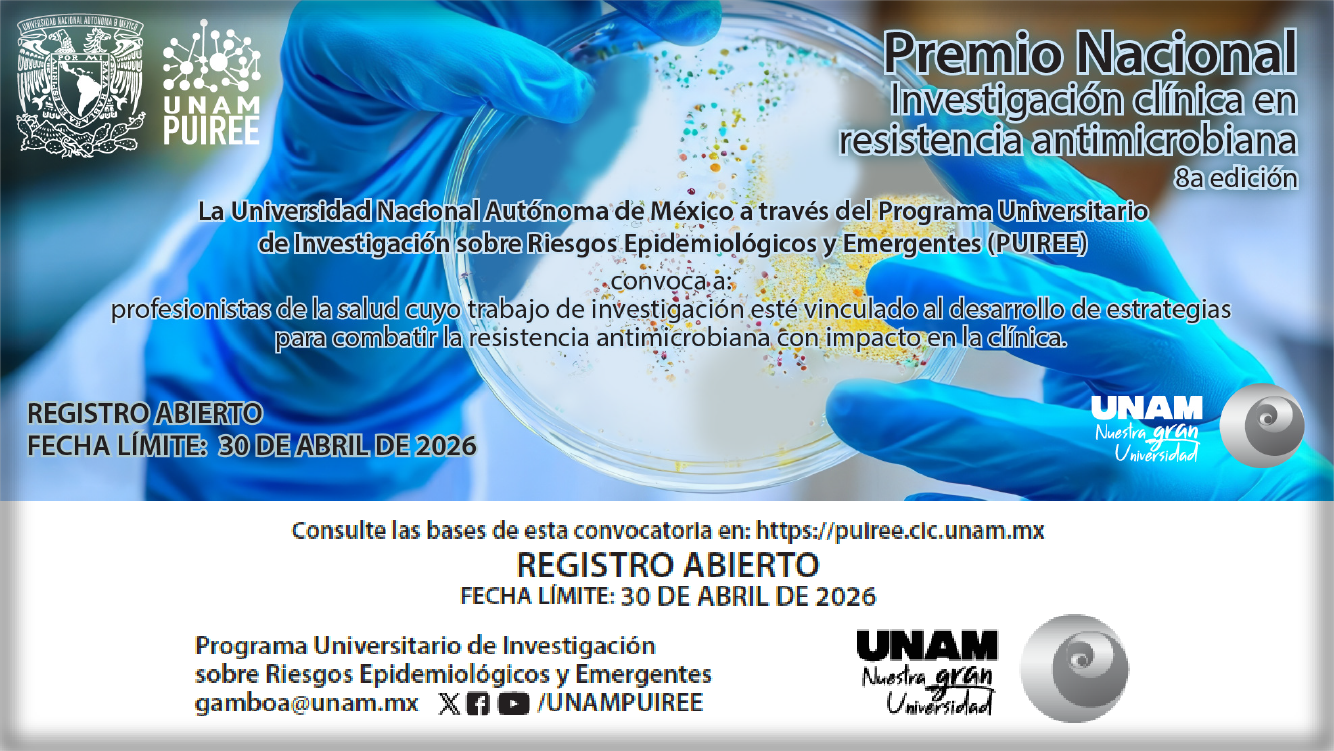

Portal de Divulgación Universitario
Universidad de la Salud
Extensión y Difusión Universitaria
Explora Nuestra Plataforma
Repositorio
Nuestra plataforma para la gestión digital del conocimiento con capacidad de almacenamiento de información y de fácil acceso para el usuario.
Divulgación
Esta es una herramienta por cuyo medio se promueve la circulación del conocimiento científico y la cultura en formatos diversos tales como carteles, infografías, artículo, videoclips, podcast, etcétera.
Conoce las novedades del portal
Ofrecemos una amplia gama de materiales, desde acervos digitales hasta publicaciones gráficas, que enriquecen la experiencia educativa y cultural de nuestros usuarios.